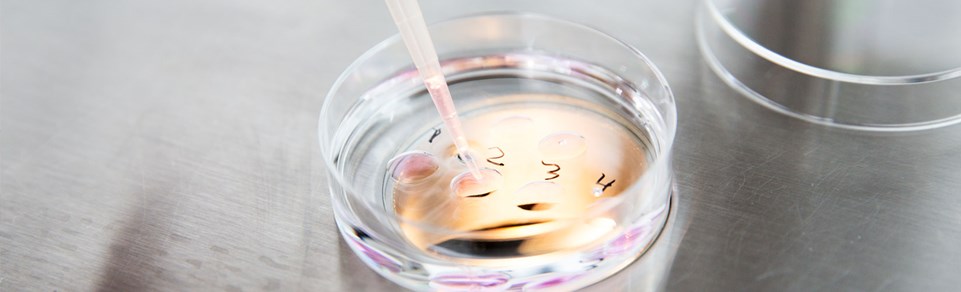

Quelle est la différence entre une insémination et une fécondation in vitro ?
FIV / FÉCONDATION IN VITRO
Lors de la fécondation in vitro, ou FIV, la fécondation a lieu dans une éprouvette, en dehors du corps de la femme.
Lors du traitement par FIV, l’ovocyte est prélevé dans les ovaires pour être fécondé avec le sperme en laboratoire.
Les ovocytes sont prélevés par le vagin par échographie. Cela se déroule sous anesthésie locale. Les ovocytes sont fécondés en laboratoire, soit en ajoutant environ 100 000 spermatozoïdes à chaque ovocyte (FIV classique), soit en introduisant un seul spermatozoïde directement dans l’ovocyte (micro-insémination, ICSI).
L’ovocyte est incubé pendant 2 à 5 jours avant d’être replacé dans l’utérus pour poursuivre son développement normal.
Lors d’une FIV, les ovaires de la femme sont stimulés pour produire plus d’ovocytes que pendant un cycle spontané. Cela signifie qu’il est possible de prélever plus d’un ovocyte pour une FIV. Au cours d’un cycle normal, la femelle ne produit généralement pas plus d’un ovule. Le fait d’avoir plusieurs ovules augmente la probabilité de trouver les bons ovules pour la fécondation.
Le traitement par FIV est recommandé dans les cas où la femme a les trompes de Fallope obstruées ou est atteinte d’endométriose et si la qualité du sperme de l’homme est médiocre ou si des causes inexpliquées d’infertilité sont présentes. Il existe différentes approches médicales du traitement par FIV qui sont adaptées aux besoins de chacun.
Environ 5 % de tous les enfants danois naissent aujourd’hui après un traitement par FIV.
INSÉMINATION
L’homme soumet un échantillon de sperme qui est trié au laboratoire. Les spermatozoïdes sont ensuite insérés dans la partie supérieure de l’utérus à l’aide d’un fin cathéter en plastique. En général, cette méthode est complètement indolore et dure à peine quelques minutes.
Les spermatozoïdes sont injectés dans l’utérus de manière que 100 fois plus de spermatozoïdes que d’habitude atteignent l’ovule.
Le traitement d’insémination peut être effectué lors d’un cycle naturel. Cependant, l’expérience montre que les chances de grossesse sont doublées en cas de stimulation hormonale, laquelle permet la libération de plus d’un ovule. La stimulation hormonale permet généralement de produire 2 à 3 ovules au lieu d’un seul comme c’est le cas au cours d’un cycle naturel. Plus il y a d’ovocytes, plus la probabilité de grossesse est grande.
L’insémination est réalisée pendant les heures où se produit l’ovulation. Le moment de l’insémination est déterminé par échographie. Lorsqu’au moins un ovocyte est mature, la femme se fait une injection qui déclenche l’ovulation 36 heures plus tard. L’insémination se fait alors dans l’utérus.
Pour en savoir plus :